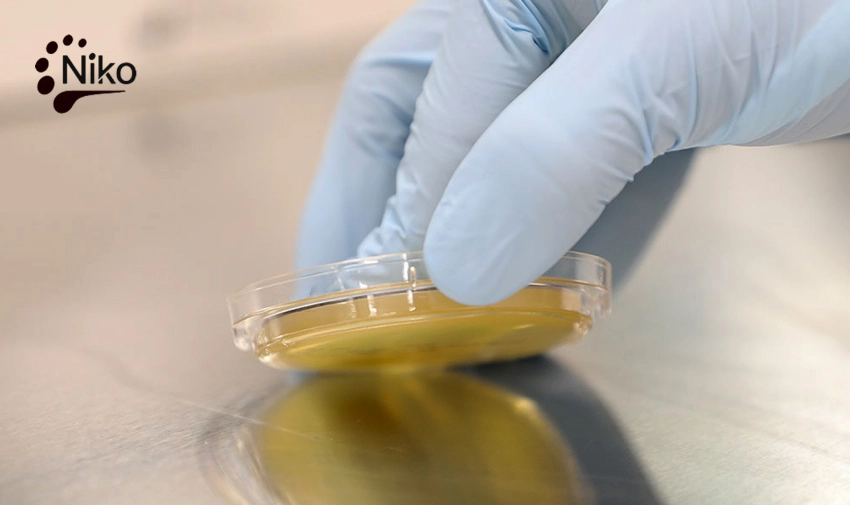

کانتکت پلیت یا پلیت روداک (RODAC) یک پتری دیش محدب و تخصصی برای پایش میکروبی سطوح است که با تماس مستقیم سطح آگار (یا سطح آماده نمونه برداری) با میز کار، تجهیزات، دستکش، بسته بندی و سایر سطوح، امکان اندازهگیری سریع آلودگی میکروبی را فراهم میکند. این محصول به صورت یکبار مصرف و استریل عرضه میشود تا ریسک آلودگی متقاطع به حداقل برسد.
ویژگیهای پلیت تماسی
- قطر سطح تماس ۵.۵ سانتی متر (مناسب نمونه برداری سطحی استاندارد)
- جنس: پلاستیک شفاف و با کیفیت
- استریل و آماده مصرف (بسته بندی استریل)
- طراحی مناسب پایش سطحی؛ کف محدب (Convex) برای تماس یکنواخت تر با سطح صاف (Flat)
- مناسب برای کنترل آلودگی سطحی در محیطهای حساس (کلینروم، صنایع و آزمایشگاهها)
| توضیحات | مشخصه |
| پلیت تماسی (کانتکت پلیت / پلیت روداک) | نام محصول |
| ۵.۵ سانتیمتر (۵۵ میلیمتر) | قطر پلیت |
| یکبار مصرف، مخصوص نمونه برداری سطحی (Surface Monitoring) | نوع محصول |
| پلاستیک شفاف با گرید آزمایشگاهی | جنس |
| استریل و آماده مصرف | وضعیت استریل |
| گاما / اتیلن اکساید | روش استریلسازی |
| مناسب تماس مستقیم با سطح | طراحی |
| پایش میکروبی سطوح، کنترل کیفی، کلینروم، صنایع غذایی/دارویی/آزمایشگاهی | کاربرد |
| بستهبندی استریل جهت جلوگیری از آلودگی متقاطع | بستهبندی |
| یک بار مصرف | نحوه مصرف |
مزایای استفاده از کانتکت پلی (پلیت روداک)
- نمونه برداری سریع و ساده بدون نیاز به سوآب
- افزایش دقت پایش بهداشتی و امکان ردیابی نقاط آلوده روی خطوط تولید
- کاهش خطای اپراتور و استانداردسازی فرآیند نمونهبرداری سطحی
- کاهش آلودگی متقاطع به دلیل ماهیت یکبار مصرف و بستهبندی استریل
موارد مصرف پلیت تماسی ۵.۵ سانت
- پایش میکروبیولوژیک سطوح در صنایع دارویی، غذایی، تجهیزات پزشکی و آرایشی-بهداشتی
- کنترل بهداشتی اتاق تمیز (Cleanroom)، میزها، هودها، دستگیرهها و سطوح پرتردد
- ارزیابی اثربخشی ضدعفونیکردن و نظافت صنعتی (قبل/بعد از عملیات)

دیدگاهها
هیچ دیدگاهی برای این محصول نوشته نشده است.